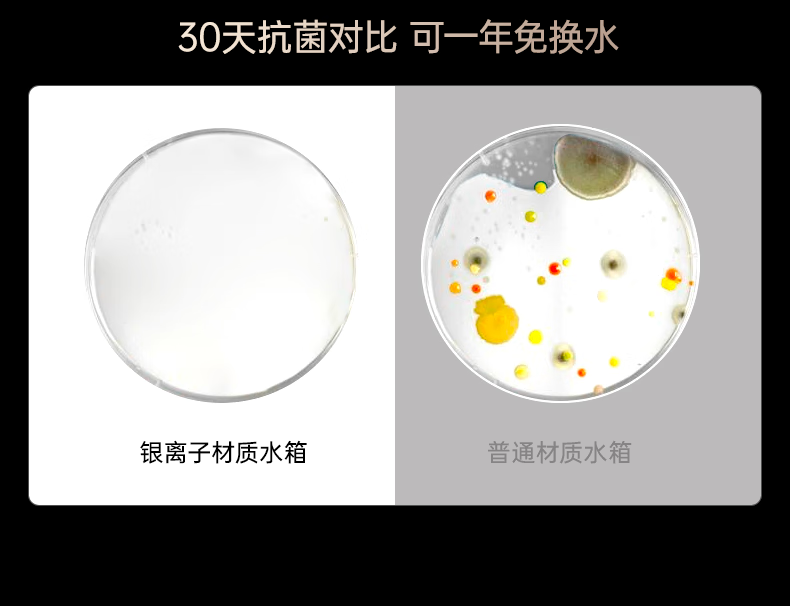

YOU MEI R7 rowing machine household foldable hydromagnetic dual-resistance smart fitness equipment fat-burning comprehensive training rowing machine Hongmeng Zhilian self-generated foldable (walnut) upgraded 16 blades
19,992.00تومان
- Stock: In Stock
- Model: j10196695044629
- Weight: 0.10kg
- Dimensions: 500.00cm x 500.00cm x 500.00cm
Create unlimited custom product blocks and display them in accordions or tabs or open blocks. Each block can be assigned to all products at once or specific products according to advanced criteria.
Create unlimited custom product blocks and display them in accordions or tabs or open blocks. Each block can be assigned to all products at once or specific products according to advanced criteria.